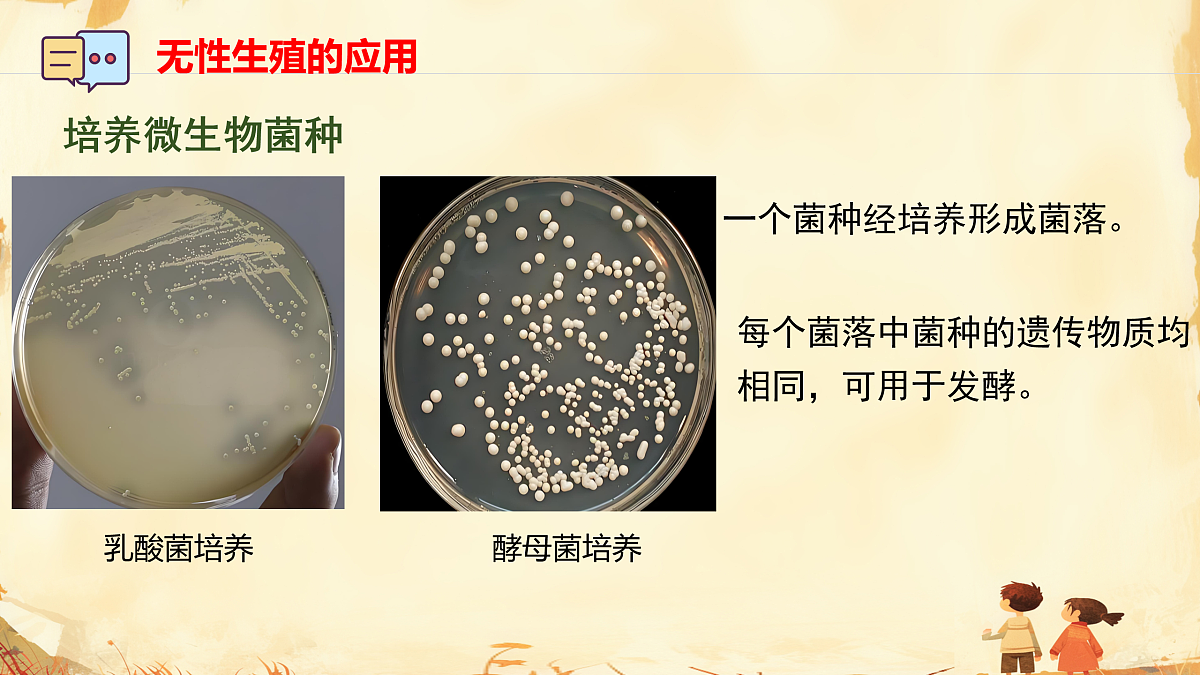
17947575第8页

人教版(2024)八年级下册(2024)第一节 无性生殖多媒体教学课件ppt
展开 这是一份人教版(2024)八年级下册(2024)第一节 无性生殖多媒体教学课件ppt,共22页。PPT课件主要包含了第一节无性生殖,学习目标,竹子开花,竹笋生长,植物利用营养器官生殖,无性生殖的特点和意义,无性生殖的特点,无性生殖的意义,培养微生物菌种,无性生殖的应用等内容,欢迎下载使用。
6.1.1 无性生殖
科学探究:尝试描述植物嫁接或扦插的基本操作流程,能基于植物细胞全能性理解组织培养的原理,初步形成动手实践与科学探究的意识。
生命观念:准确阐述无性生殖的概念,列举出芽生殖、分裂生殖、营养生殖等常见无性生殖方式,理解不同生物无性生殖的生物学意义。
科学思维:通过对比不同生物的生殖方式,归纳无性生殖的核心特征,提升分类、归纳与逻辑推理能力。
态度责任:结合农业生产、园艺栽培中的实例,分析无性生殖的应用价值,关注生物科技在生产生活中的作用,增强科学应用的责任意识。
你见过竹子开花吗?很少开花的竹子如何长成郁郁葱葱的竹林呢?
竹有很多地下茎(即竹鞭),地下茎分节,节上的芽可以发育为竹笋,竹笋长成新竹。
除了椒草,还有哪些植物能通过叶来繁殖?哪些植物能通过根或茎来繁殖?
以上几种生物的生殖方式有什么共性?
它们都是不经过两性生殖细胞的结合,由母体直接产生新个体,这种生殖方式称为无性生殖。
1.后代只具有母体的遗传特性,有利于保持母体的优良性状。
一些生物通过无性生殖可迅速繁殖大量后代,从而能够快速占领环境,这有利于物种的生存和发展。
一个菌种经培养形成菌落。
每个菌落中菌种的遗传物质均相同,可用于发酵。
定义:剪取一段枝条,把枝条的下部插入湿润的土壤或水中,在适宜的温度下,枝条下部长出根,上部发芽,最后长出一个新个体。
斜切增加吸收水分的面积
待生根、长出新叶后移栽
定义:把一个植物体的芽或枝(接穗),接在另一个植物体(砧木)上,使结合在一起的两部分长成一个完整的植物体。
用芽作为接穗的嫁接方式
用枝作为接穗的嫁接方式
嫁接成功的关键:嫁接时应当使接穗和砧木的 紧密结合,以确保接穗成活。
为接穗提供固定场所为接穗提供营养
黑枣与柿树的跨界热恋,以嫁接为媒,余生枝繁果茂,甜意不散。
黑枣具有更好的抗性,缺点是果子小,不好吃,经济效益低
柿子树结果率高,但有性生殖结果时间长
无性生殖的应用:如何选择接穗与砧木进行嫁接?
嫁接成活的植株所结的果实为______品种。
嫁接优点:加快开花结果,基本能保持接穗原来的优良特性
无性生殖的应用:黑枣和柿树跨界之恋,嫁接为媒。
无性生殖的应用:嫁接举例:培育花卉
在无菌条件下,将植物的茎尖、叶片、茎段等,在人工配置的培养基上培养,并诱导它们发育成“试管苗”,进而得到完整植株。
取材少,在短时间内快速大量繁殖
无性生殖的应用:植物组织培养
1.自然界中很多生物能进行无性生殖,下列有关说法不正确的是( )A.无性生殖不经过两性生殖细胞的结合B.乳酸菌的分裂生殖是无性生殖C.水螅的出芽生殖是无性生殖D.无性生殖后代只具有母体的遗传特性,不利于物种的生存和发展
2. (2025•黑龙江)剪取绿萝的一段枝条,插入盛水的花瓶中,能长成一个新个体的繁殖方式是( )A.扦插B.压条C.嫁接 D.组织培养
3.(2025•广东)园艺师使一株三角梅长出多种颜色的“花”(花苞片),所用技术最可能是( )A.扦插 B.嫁接 C.种子繁殖 D.组织培养
相关课件
这是一份人教版(2024)八年级下册(2024)第一节 无性生殖课文内容ppt课件,共14页。
这是一份初中生物人教版(2024)八年级下册(2024)第一节 无性生殖教案配套课件ppt,共26页。PPT课件主要包含了导入草莓园的奇迹,概念无需恋爱的繁殖,无性生殖的核心定义,类型自然界的复制术,形成层,嫁接注意事项,无性生殖的应用,无性生殖的优点,无性生殖的方法,总结与思考等内容,欢迎下载使用。
这是一份生物八年级下册(2024)第一节 无性生殖说课ppt课件,共24页。PPT课件主要包含了学习目标,无性生殖的概念,思考·讨论,无性生殖的应用,课堂小结,练习与应用,概念检测等内容,欢迎下载使用。
相关课件 更多
- 1.电子资料成功下载后不支持退换,如发现资料有内容错误问题请联系客服,如若属实,我们会补偿您的损失
- 2.压缩包下载后请先用软件解压,再使用对应软件打开;软件版本较低时请及时更新
- 3.资料下载成功后可在60天以内免费重复下载
 免费领取教师福利
免费领取教师福利 






.png)





